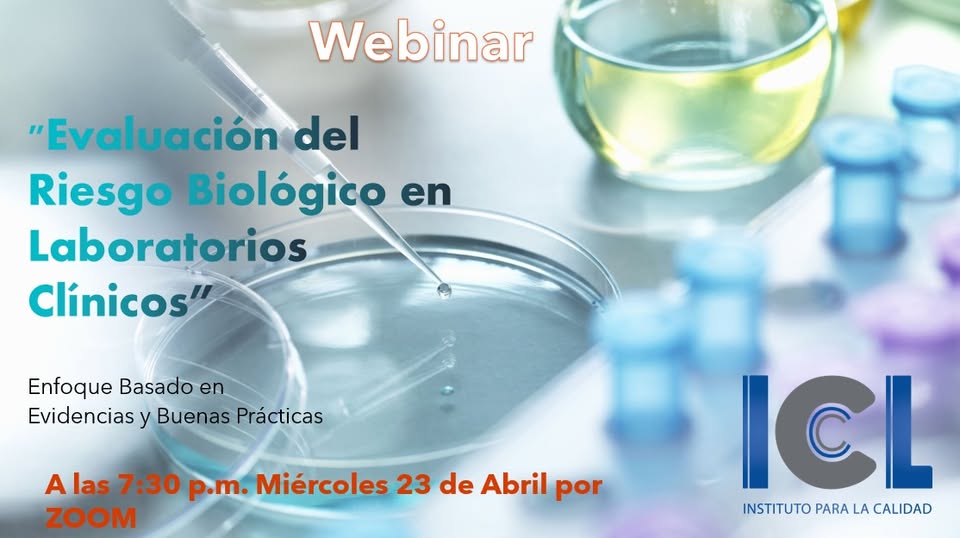

Cursos webinar del 2025
Cursos mes de Julio – 2021
Cursos mes de Agosto – 2021
Cursos mes de Septiembre – 2021
Cursos mes de Octubre – 2021
Cursos mes de Noviembre – 2021
Cursos mes de Diciembre – 2021
Cursos mes de Enero – 2022
Cursos mes de Febrero – 2022
Cursos mes de Marzo – 2022
Cursos del mes de Abril – 2022